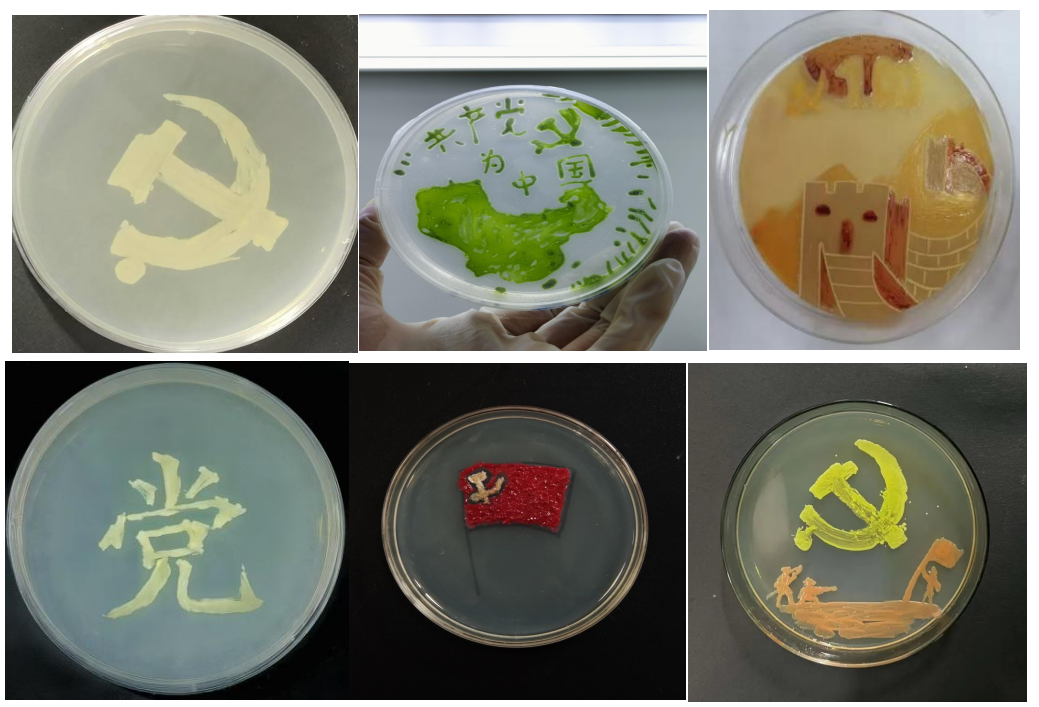

十大外围足球平台app党委开展“菌彩飞扬,党心绘梦”微生物绘画创意展活动
发布时间:2024-12-24      来源:十大外围足球平台app    点击:[]    分享到:
为进一步加强员工党员党性修养,坚定理想信念,激发爱国热情,近期,由十大外围足球平台app党委主办,“红色基因”辅导员工作室承办,硕士微生物党支部及党建工作站协办开展了“菌彩飞扬,党心绘梦”微生物创意展活动。
本次活动由线上作品征集、线上投票、优秀作品校园展示三阶段构成。自 12 月上旬活动正式启动以来,共收到各类投稿作品 111 份。同学们把微生物当作别具一格的 “画笔” 与 “颜料”,运用所学专业知识,依靠扎实的专业技能,进行主题创作,有的同学用菌液书写 “党” 字,画党旗党徽;有的同学以党史故事为灵感,创作出一幅幅充满巧思的画作,将爱国爱党之情在作品中生动展现。线上投票环节反响热烈,吸引了 876 人次积极参与,广大师生纷纷为喜爱的作品投出宝贵一票。经过综合评审,10 份优秀作品脱颖而出,相关获奖作品在员工社区皂角树广场、“筑梦先锋”党员服务角、党建工作站等进行陆续展出,吸引了众多师生驻足欣赏。
本次活动是十大外围足球平台app党委探索“党建+”工作模式,创新党员教育活动的有益尝试,通过“党建+人才培养、科学研究、社会服务、红色文化传承”,将“+什么、怎么+、如何+”与公司事业发展全链条贯通、全方位融合。在独具特色的教育活动中点燃员工钻研专业知识的热情,更筑牢党性根基,引领青年学子在学业精进之路上传承红色基因,成长为有理想,敢担当,能吃苦肯奋斗的新时代好青年。